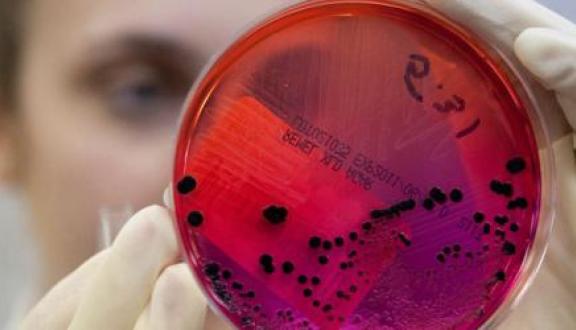

Cristina Da Rold

Freelance (data) journalist & science communicator.
Mi occupo di giornalismo e comunicazione della scienza come freelance. Soprattutto in rete e soprattutto data-driven.
Lavoro per la maggior parte su temi legati a salute, sanità, nuove tecnologie, economia.
Twitter: @CristinaDaRold
di Cristina Da Rold
10 Dec 2017
di Cristina Da Rold
17 Nov 2016
di Cristina Da Rold
9 Jun 2016
di Luca Carra, Francesco Aiello, Michele Bellone, Giuseppe Nucera, Cristina Da Rold
14 Feb 2014